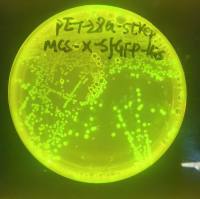
产品图

上海海吉浩格生物科技有限公司免费会员
公司介绍
http://www.hedgehogbio.com/上海海吉浩格生物科技有限公司
供应产品

pJOE8999 枯草芽孢杆菌CRISPR-Cas9系统基因编辑载体
价格:¥1098

pJOE8999 枯草芽孢杆菌CRISPR系统基因编辑载体
价格:¥468
pET28-Strep-MCS-X-sfGFP-His可视化原核表达载体双标签
价格:¥550

pAAV-RC2 ,pAAV-RC腺病毒相关载体 血清型2
价格:¥550

pmCherry-EGFP-hLC3B人源自噬红绿双标载体
价格:¥550

pMCS-hRLuc-TK-Luc双荧光素酶在一个质粒上
价格:¥550

pCHO-GS3 GS 系统的表达载体 抗体表达载体
价格:¥2098

lentiCRISPRv2 哺乳动物基因敲除载体 慢病毒 CRISPR/Cas9
价格:¥550
详细信息
| 公司名称 | 上海海吉浩格生物科技有限公司 | 企业类型 | 民营 |
| 经营模式 | 企业地区 | 上海-杨浦区 | |
| 经营地址 | 杨浦区 | 主要产品 | |
| 公司成立时间 | 2015 | 公司网址 |
免责声明:以上所展示的信息由企业自行提供,内容的真实性、准确性和合法性由发布企业负责,丁香园对此不承担任何保证责任。


